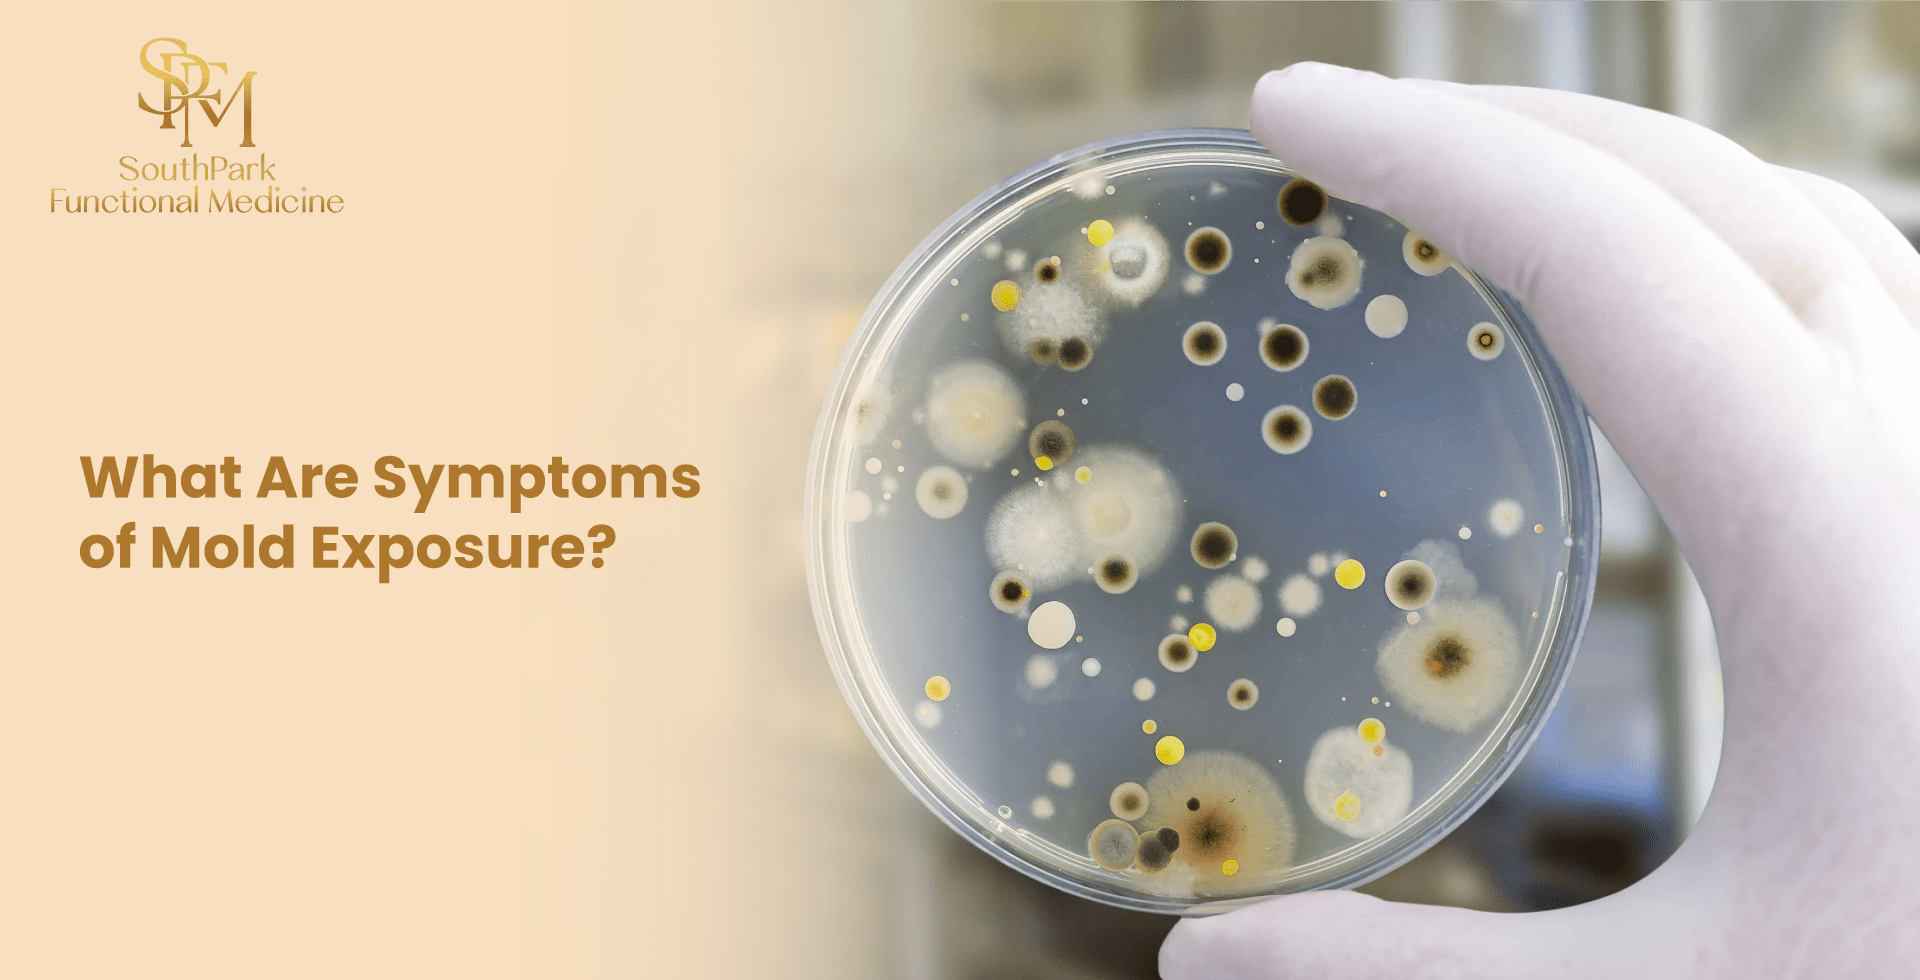
What Are Symptoms of Mold Exposure?

-
5 Digestive Disorders That Cause Weight Gain
Weight gain is often blamed on too much sugar and not enough exercise. But if you’re practicing healthy behaviors and still gaining weight, digestive issues…
-
Functional Medicine for Autoimmune Disease Treatment
Autoimmune diseases are chronic conditions that often require lifelong treatment. Functional medicine helps you uncover the root causes of your disease so you can take…
-
What Is a Functional Medicine Approach to Diet?
Nutrition is a powerful tool that, when used properly, can significantly contribute to protecting your health. A functional medicine diet is a personalized nutrition plan…
-
What’s the Connection Between Acid Reflux and Diabetes?
Acid reflux and diabetes often occur together, as one condition increases your risk for the other. Coping with symptoms such as bloating, heartburn, and chest…
-
Chronic Pain Syndrome vs Fibromyalgia
Chronic pain syndrome and fibromyalgia are sometimes confused with one another, but understanding their key differences can help you navigate your pain and find the…
-
What Are Symptoms of Mold Exposure?
Mold is a fungus and a natural part of our environment because it can grow in places where moisture and oxygen are present. It is…
-
What’s the Difference Between Psoriasis and Eczema?
Psoriasis and eczema are often mistaken for one another, as they share many similarities. Understanding their differences can help you stay informed, enabling you to…
-
Foods to Avoid with MCAS: Key Mast Cell Activation Triggers
Mast Cell Activation Syndrome (MCAS) is often a complex condition due to its wide range of symptoms that can cause numerous issues throughout the body.…
-
The GI-MAP Test: How It Can Help
Your gut is commonly known as your “second brain,” and this nickname has value. The health of your digestive system affects your body beyond your…
-
Functional Blood Tests Explained, And Why You Need a Functional Doctor
Routine blood tests are essential for preventive care, as they can detect problems early and offer insight into your general health status. Functional blood tests,…